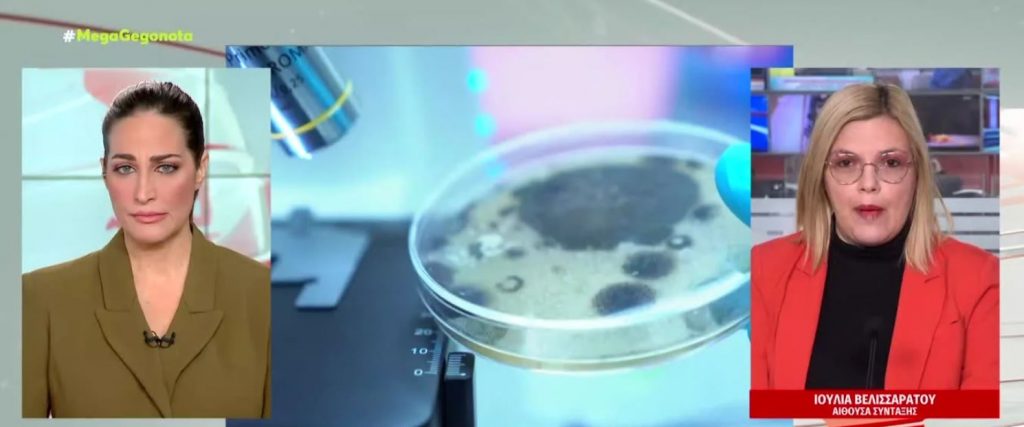

Σοκ έχει προκαλέσει ο ξυλοδαρμός του καθηγητή από ομάδα κουκουλοφόρων μέσα στο αμφιθέατρο του οικονομικού πανεπιστημίου. Οι αστυνομικοί προσπαθούν μέσα απο μαρτυρίες φοιτητών, κάμερες και κινητά τηλέφωνα, να σκιαγραφήσουν το προφίλ της ομάδας και να χαρτογραφήσουν το δρομολόγιο που ακολούθησαν αλλά και πως κατάφεραν να μπουν μέσα στην αίθουσα. Πάντως οι αστυνομικοί της ασφάλειας ψάχνουν να δουν, ποιοί γνώριζαν τις δικαστικές διαμάχες που είχε τα τελευταία χρόνια ο καθηγητής και αν ήθελαν για αυτό τον λόγο να του επιτεθούν.
Το απίστευτο περιστατικό άγριου ξυλοδαρμού καθηγητη εντός της ΑΣΟΕΕ προκάλεσε την παρέμβαση της Εισαγγελίας Πρωτοδικών.
Λίγο πριν τις 4 το απόγευμα 20 περίπου κουκουλοφόροι εισέβαλαν στο αμφιθέατρο του πανεπιστημίου όπου παρέδιδε μάθημα ο εν λόγω καθηγητής και άρχισαν να του επιτίθενται αρχικά λεκτικά και στη συνέχεια να τον ξυλοκοπούν.
Όλα αυτά μπροστά στα έντρομα μάτια φοιτητών… Την ίδια ώρα σύμφωνα με τις καταγγελίες οι κουκουλοφόροι έδειραν και φοιτητές οι οποίοι προσπάθησαν να υπερασπιστούν τον καθηγητή.
Η επίθεση διήρκεσε λίγα λεπτά και στη συνέχεια ο καθηγητής Χρηματοοικονομικής Διοίκησης μετέβη μόνος του στον Ευαγγελισμό για αξονική τομογραφία. Ευτυχώς τα τραύματα του ήταν ελαφρά.
Η προϊσταμένη εισαγγελίας Πρωτοδικών Αθηνών Σωτηρία Παπαγεωργακοπούλου έδωσε εντολή για τη διενέργεια προκαταρκτικής έρευνας προκειμένου να διερευνηθεί αν έχουν τελεστεί μεταξύ άλλων οι αξιόποινες πράξεις, της επικίνδυνης σωματικής βλάβης, της διατάραξης δημόσιας υπηρεσίας και της παράνομης βίας.
Σύσσωμη η πολιτική ηγεσία καταδίκασε την επίθεση του άγριου ξυλοδαρμού.
Ο καθηγητής φέρεται να υποστήριξε στους αστυνομικούς, ότι πίσω από την επίθεση κρύβονται τρεις καθηγητές με τους οποίους βρίσκεται σε δικαστική διαμάχη.
Οι συγκεκριμένοι καθηγητές αναμένεται να κληθούν να δώσουν κατάθεση.
Ο δικηγόρος ενός εκ των καθηγητών που εμπλέκει το θύμα της επίθεσης επρόκειτο σήμερα να καταθέσει μήνυση σε βάρος του καθηγητή.
Την ίδια ώρα είναι σε εξέλιξη προκαταρκτική έρευνα μετά από καταγγελίες συναδέλφων του για παιδεραστία, ενώ στο παρελθόν του είχε ασκηθεί δίωξη για πλημμελήματικη τοκογλυφία υπόθεση για την οποία αναμένεται να εκδικαστεί την Παρασκευή.
Οι αστυνομικές αρχές εξετάζουν καρέ καρε τα βίντεο ντοκουμέντο της επίθεσης και παίρνουν καταθέσεις από τους φοιτητές που ήταν αυτόπτες μάρτυρες του περιστατικού σε μια προσπάθεια να εντοπίσουν τους ανθρώπους που κρύβονται πίσω από τον αγριο ξυλοδαρμό του καθηγητή.
Μήνυση κατά του καθηγητή από συνάδελφό του
Μήνυση κατά του καθηγητή του Οικονομικού Πανεπιστημίου που δέχτηκε επίθεση χθες από κουκουλοφόρους καταθέτει στην Εισαγγελία Πρωτοδικών Αθηνών ένας εκ των τριών συναδέλφων του που τον έχουν καταγγείλει για παιδεραστία.
Όπως ισχυρίζεται ο μηνυτής, στρέφεται εις βάρος του γιατί τον φωτογραφίζει ως ηθικό αυτουργό της εις βαρος του επίθεσης.
Σύμφωνα με τον δικηγόρο του μηνυτή, κ. Άγη Τάτση, κατατέθηκε μήνυση για συκοφαντική δυσφήμιση και θα ζητηθεί η αυτόφωρη σύλληψη του καθηγητή.
Σύμφωνα με πληροφορίες μεταξύ των δύο ανδρών υπάρχει αντιδικία, καθώς πριν από μερικά χρόνια ήταν συνέταιροι σε επενδυτική εταιρία και το θύμα ξυλοδαρμού είχε αποχωρήσει, γιατί θεωρούσε πως ο συνέταιρός του προχωρούσε σε έκνομες ενέργειες και ότι κοροϊδεύει τους επενδυτές.